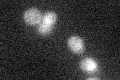
YBR085W
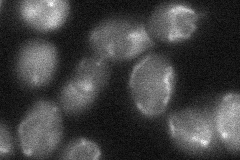
YBR085W
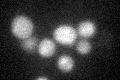
YBR085W

View description
Mitochondrial inner membrane ADP/ATP translocator, exchanges cytosolic ADP for mitochondrially synthesized ATP; expressed under anaerobic conditions; similar to Pet9p and Aac1p; has roles in maintenance of viability and in respiration
Localization:
Intensity:
Fold change:
Significance:
-
C’ GFP library in SD
mitochondria15.91 -
N' NOP1pr-GFP in SD

mitochondria0 -
N' TEF2pr-mCherry in SD

mitochondria123.863 -
N' NATIVEpr-GFP in SD

punctate,mitochondria19.9798 -
N' TEF2pr-VC and Cyto-VN in SD
mitochondria31.3515 -
C’ GFP library in SD+DTT
mitochondria14.920.93No -
C’ GFP library in SD+H2O2

mitochondria14.970.94No -
C’ GFP library in Starvation Media

mitochondria18.621.16No -
C’ GFP library on the background of Pup2-DaMP

mitochondria -
C’ GFP library on the background of CCT mutant

mitochondria17.09981.07425No
